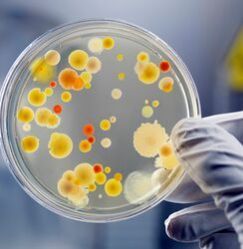

Complete Microbial Analysis Services
Get Price Quote
We are providing complete microbial analysis services. .\r\n> complete biochemical analysis of bacteria.\r\n> phenotypic identification through fatty acid methyl ester (fame) of bacteria, fungi, yeast and actin.\r\n> identification of bacteria, fungi, yeast, actin through rdna sequencing and maldi tof analysis.\r\n> polyphasic report match with fame & dna on dna sherlock software\r\n> probiotic ,microbial testing ,identification of fungal bacterial, yeast identification by maldi-tof, dna sequencing, fatty acid and all types of algal related services.
...more